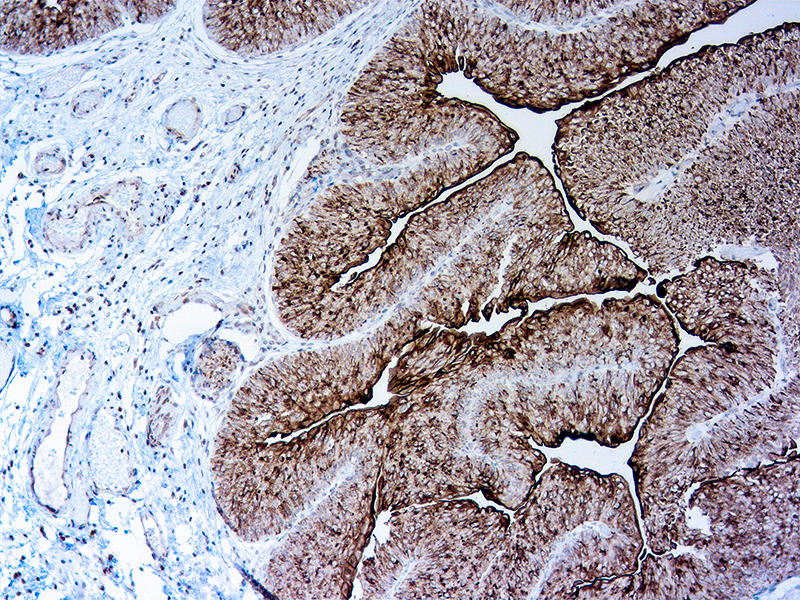

Uroplakins (UPs) are a family of transmembrane proteins (UPs Ia, Ib, II and III) that are specific differentiation products of urothelial cells. In nonneoplastic mammalian urothelium, UPs are expressed in the luminal surface plasmalemma of superficial (umbrella) cells, forming complexes of 16nm crystalline particles. UPIII isspecific for tumors of urothelial origin and, when used in combination with other markers, can aid in the diagnosis of primary and metastatic tumors.
Uroplakin III
Description
Additional information
| Catalog No. | Mob594 Concentrated, PDM594 Prediluted |
|---|---|
| Clone | AU1 |
| Isotype | IgG1 |
| Immunogen | Raised in mouse using AUM preparation from bovine urinary bladder as the immunogen. |
| Species | Mouse |
| Cellular Localization | Cytoplasmic and Membranous |
| Positive Control Tissue | Bladder Carcinoma |
| Pretreatment | EDTA Buffer pH8.0 |
| Incubation & Temperature | 30 min @ RT |
| Intended Use | IVD |
| Detection System | PolyVue Plus – Two Step Detection System Montage PolyVue Plus Auto Detection System for Montage 360 System |
| Description/Type | Mouse Monoclonal Antibody |
| Format | Tissue Culture Supernatant |
DATASHEETS & SDS
DATASHEETS & SDS
| Download Datasheet |
| Download SDS Sheet – OSHA |
REFERENCES
REFERENCES
I. Moll R, et al. Uroplakins, specific membrane proteins of urothelial umbrella
cells, as histological markers of metastatic transitional cell carcinomas. Am J
Pathol. 1995; 147:1383-97.
II. Olsburgh J, et al. Uroplakin gene expression in normal human tissues and
locally advanced bladder cancer. J Pathol. 2003; 199:41-9
III. Parker DC, et al. Potential utility of uroplakin III, thrombomodulin, high
molecular weight cytokerain and cytokeratin 20 in noninvasive, invasive, and
metastatic urothelial (transitional cell) carcinomas. Am J Surg Pathol. 2003;
27:1-10
IV. Ohtsuka Y, et al. Loss of uroplakin III expression is associated with a poor
prognosis in patients with urothelial carcinoma of the upper urinary tract.
BJU Int. 2006; 97:1322-6.
Reviews (0)
Only logged in customers who have purchased this product may leave a review.

Reviews
There are no reviews yet.